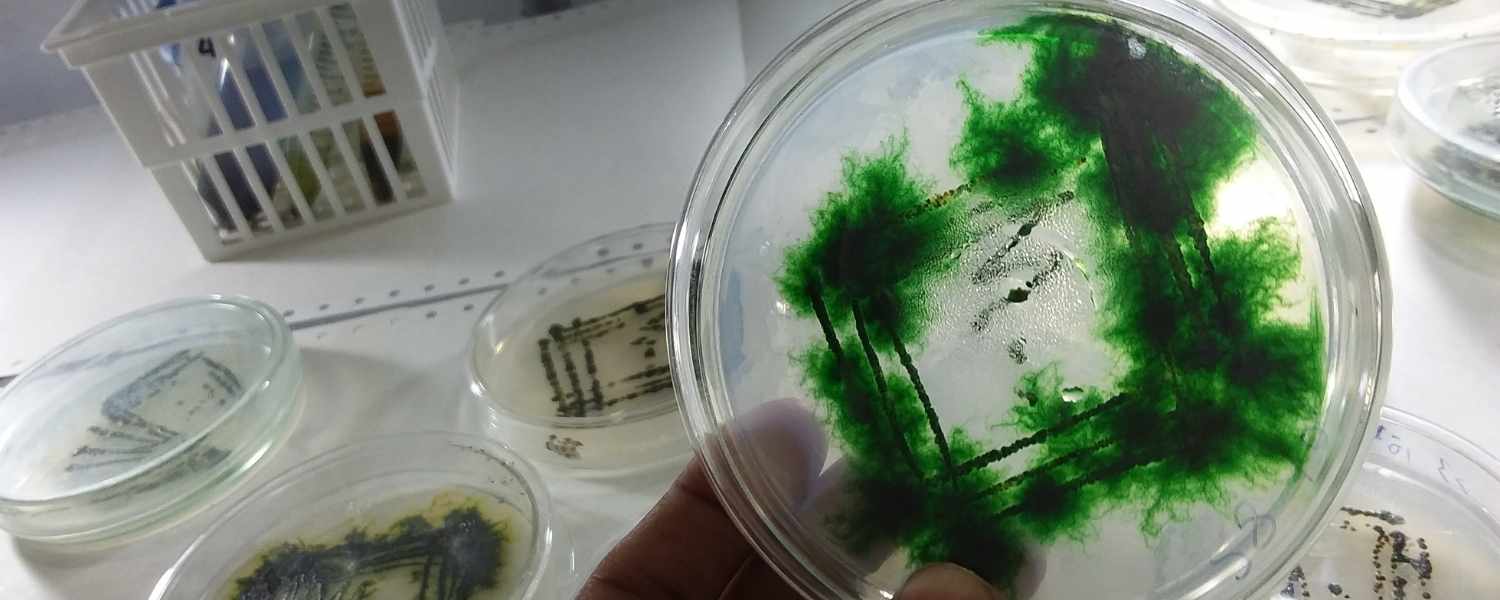

La spiruline est un superaliment riche en protéines, vitamines, et antioxydants. Mais sa qualité peut considérablement varier en fonction des conditions de culture, du mode de transformation et du contrôle sanitaire. C'est pourquoi une spiruline de mauvaise qualité peut présenter des risques pour votre santé !
Dans cet article, vous découvrirez :
- ⚠️ Les dangers d’une spiruline de mauvaise qualité
- ✅ Comment bien choisir votre spiruline ?
- 🏆 Et enfin, quelle est la meilleure spiruline pour vous.
Prêt ? Alors poursuivez votre lecture !
⚠️ Les dangers d'une spiruline de mauvaise qualité
Qu’est-ce qu’une spiruline de mauvaise qualité, me direz-vous ? Eh bien, c’est une spiruline qui contient bien plus que les nutriments que vous êtes en droit d’attendre. Et pas des bons pour la santé ! Impuretés, résidus de métaux lourds, contaminants microbiens ou encore additifs indésirables peuvent s’y retrouver, compromettant non seulement ses bienfaits, mais aussi votre santé.
Voici les principaux indésirables que l'on retrouve dans les spirulines bon marché :
1. Présence de métaux lourds et pollution
Certaines spirulines cultivées dans des eaux polluées peuvent contenir des métaux lourds toxiques comme le plomb, l'arsenic, le cadmium et le mercure. Ces substances, une fois ingérées, peuvent provoquer :
- Problèmes hépatiques et rénaux (à long terme, cela peut mener à une insuffisance rénale).
- Troubles neurologiques (état de fatigue chronique, pertes de mémoire, difficultés de concentration).
- Risque accru de cancer, notamment pour les organes filtrants comme le foie.
2. Contamination par des bactéries et toxines
La spiruline mal contrôlée peut contenir des bactéries pathogènes et des toxines produites par d’autres algues, notamment les microcystines. Ces substances sont toxiques pour :
- Le foie (éléments hépatotoxiques provoquant des inflammations ou des lésions hépatiques).
- Le système digestif (épisodes de diarrhée, nausées, vomissements).
- Le système nerveux (en cas d’ingestion prolongée, risques neurotoxiques signalés par certaines études).
3. Faible valeur nutritionnelle
Une spiruline de mauvaise qualité peut perdre ses nutriments essentiels à cause de :
- Un séchage à haute température (altère les vitamines et acides aminés).
- Un stockage inadapté (à l'air libre, elle peut s'oxyder et perdre ses propriétés nutritives).
✅ Comment choisir une spiruline de qualité ?
Pour écarter le danger, voici plusieurs points à vérifier avant d'acheter votre spiruline :
- Vérifiez les labels et certifications : AB, Ecocert, USDA Organic.
- Préférez des fournisseurs européens (évitez les spirulines chinoises souvent moins contrôlées).
- Optez pour une spiruline analysée en laboratoire (évitez celles sans tests sur les métaux lourds).
- Choisissez une spiruline séchée à basse température pour préserver les nutriments.
Nous pourrions épiloguer encore davantage sur ce point, alors si vous souhaitez approfondir vos connaissance sur ce sujet, consultez nos articles dédiés :
FAQ : Réponses aux questions courantes sur les dangers de la spiruline
Quels sont les effets secondaires de la spiruline ?
En cas de spiruline de mauvaise qualité : intoxication, troubles digestifs, douleurs musculaires.
Une bonne spiruline peut aussi provoquer des ballonnements si la dose est trop élevée au début.
Comment savoir si une spiruline est contaminée ?
Si elle dégage une odeur forte d’ammoniac ou de poisson, c'est mauvais signe. Enfin, vérifiez toujours la provenance et les analyses microbiologiques (obligatoirement fournies par le fabricant).
Pourquoi certaines spirulines sont plus chères que d'autres ?
La spiruline est un superaliment extraordinaire, mais seule une spiruline de qualité garantit des bienfaits sans danger. Avant d’acheter, vérifiez toujours son origine, ses certifications et les tests effectués.
Nous ne pouvons pas le nier : la spiruline est un superaliment extraordinaire. Mais seule une spiruline de qualité garantit des bienfaits sans danger. Alors avant d’acheter tête baissée, vérifiez toujours son origine, ses certifications et les tests effectués.
🔎 Vous voulez une spiruline pure et sûre ? Découvrez notre gamme de compléments alimentaires à base de Spiruline 100% naturels et certifiés bio.